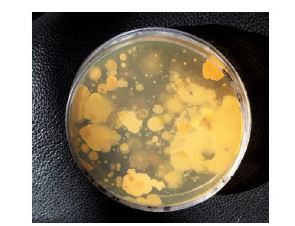
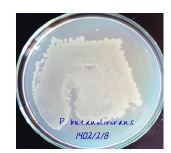

دوره 33، شماره 10 - ( دی 1404 )
جلد 33 شماره 10 صفحات 9539-9521 |
برگشت به فهرست نسخه ها
Download citation:
BibTeX | RIS | EndNote | Medlars | ProCite | Reference Manager | RefWorks
Send citation to:



BibTeX | RIS | EndNote | Medlars | ProCite | Reference Manager | RefWorks
Send citation to:
Bahrami-Nezhad M, Kavyanifard A A, Dousti B, Gilavand F, Molavi Vardanjani N. Antibacterial Activity of Bioactive Compounds of Lumbricus Rubellus Earthworm-Ectosymbiotic Bacterium Peribacillus Butanolivorans KG, against Some Gram-Negative and Gram-Positive Pathogenic Bacteria. JSSU 2026; 33 (10) :9521-9539
URL: http://jssu.ssu.ac.ir/article-1-6496-fa.html
URL: http://jssu.ssu.ac.ir/article-1-6496-fa.html
بهرامی نژاد محمد، کاویانیفرد امیرارسلان، دوستی بهروز، گیلاوند فرهاد، مولوی وردنجانی نجمه. فعالیت ضد باکتریایی ترکیب زیستفعال باکتری برون همزیست کرم خاکیLumbricus rubellus (گونه Peribacillus butanolivorans KG) علیه برخی از باکتریهای بیماریزای گرم منفی و گرم مثبت. مجله علمي پژوهشي دانشگاه علوم پزشكي شهید صدوقی يزد. 1404; 33 (10) :9521-9539
متن کامل [PDF 1288 kb]
(236 دریافت)
| چکیده (HTML) (579 مشاهده)
متن کامل: (220 مشاهده)
مقدمه
سازمان بهداشت جهانی در گزارشهای مختلف بر تهدید جهانی قریبالوقوع مقاومت آنتیبیوتیکی تأکید کرده است، بهطوریکه تا سال 2050، میزان مرگ و میر جهانی ناشی از پاتوژنهای مقاوم به آنتیبیوتیک میتواند سالانه به 10 میلیون نفر برسد (1،2). افزایش چشمگیر مقاومت پاتوژنها در برابر آنتیبیوتیکها در طول 60 سال گذشته بهعنوان یک چالش مداوم که عموما با جهش یا انتقال افقی ژن پدیدار میشود، همواره نیاز به توسعه آنتیبیوتیکهای جدید و ترکیبات آنتیبیوتیکی نوآورانه بهعنوان جایگزینهای مناسب برای آنتیبیوتیکهایی که مقاومت در برابر آنها ایجاد شده است را نشان میدهد (3). تقریباً میتوان منشأ همه آنتیبیوتیکهای مورد استفاده فعلی را در میکروارگانیسمهای مشتق شده از خاک ردیابی کرد که در این بین امیدوارکنندهترین فرصتها برای کشف و توسعه آنتیبیوتیکها، میکروارگانیسمهایی هستند که بهصورت همزیست با یک گیاه، جانور یا میکروارگانیسم دیگری در خاک زندگی میکنند (1). تکامل همزمان همزیستهای میکروبی با میزبانهای خاص خود منجر به بیان ویژگیهای بیوشیمیایی منحصربهفردی میشود که منابع غنی از متابولیتهای ثانویه با فعالیتهای زیستی قابلتوجه از نظر درمانی را فراهم میسازند (4). به عبارت دیگر، از منظر کشف دارو، در قلب سیستمهای همزیستی، محصولات طبیعی با ساختارهای متمایزی وجود دارد (5) که حداقل 40 درصد از این داربستهای شیمیایی توسط ترکیبات مصنوعی قابل فرآوری نیستند. از اینرو، این محصولات طبیعی به دلیل جهتگیریهای فضایی پیچیده و کاملاً تعریف شده خود که یک ساختار بیولوژیکی منحصربهفرد را ایجاد میکنند، نقاط شروع استثنایی در کشف دارو هستند (6). کرمهای خاکی مهمترین بیمهرگان خاک هستند و تاکنون برای بررسی عوامل درمانی بالقوه مورد استفاده قرار گرفتهاند، اگرچه باکتریهای دخیل در همزیستی آنها، حوزهای است که هنوز برای کشف و توسعه آنتیبیوتیکهای جدید بهطور گسترده ناشناخته مانده است، این در حالی است که مشخص شده است کرمهای خاکی بهعنوان حامل باکتریهای سالم خاک با خاصیت درمانی عمل میکنند (7). در میان کرمهای خاکی، Lumbricus rubellus (L. rubellus)، سابقه طولانی در استفاده دارویی بهعنوان درمان کمکی یا طب جایگزین دارد. کرم خاکی L. rubellus به گروه کرمهای خاکی اپیژئیک تعلق دارد که در ۵ سانتیمتر بالایی لایه خاک و در لایه بستر زندگی میکنند (8). از آنجاییکه لایه بستر خاک تنوع باکتریایی قابلتوجهی را در خود جای داده است، کرم خاکی L. rubellus از همزیستی متنوع باکتریایی برخوردار میباشد. اگر چه نقش درون همزیستهای L. rubellus در کشف آنتیبیوتیک بیشتر شناخته شده است، اما تنها مطالعات کمی در مورد پتانسیل ترکیبات تولید شده توسط باکتریهای برون همزیست آن بحث کردهاند، حال آنکه شواهد نشان میدهد باکتریهای برون همزیست بهطور خاص در دفاع از میزبان خود در برابر پاتوژنها نقش ایفا میکنند (9). بنابراین، غربالگری بیشتر باکتریهای برون همزیست بالقوه کرم L. rubellus، در راستای شناسایی اهداف درمانی ضد میکروبی ضرورت دارد. هدف از این مطالعه شناسایی باکتریهای برون همزیست کرم خاکی L. rubellus بهعنوان مهارکنندههای رشد برخی از باکتریهای بیماریزا است.
روش بررسی
این مطالعه پژوهشی بهصورت تجربی از اسفند ماه 1401 تا شهریور ماه 1402 در مرکز تحقیقات گیاهان دارویی مجتمع آزمایشگاهی رازی دانشگاه علوم پزشکی لرستان و آزمایشگاه تحقیقاتی دانشگاه آزاد اسلامی واحد خرمآباد انجام شد. باکتریهای مورد نظر تحقیق یعنی باسیلوس سوبتیلیس (ATCC 465)، استافیلوکوکوس اورئوس ((ATCC 25923، اشریشیا کلی (ATCC 25922) و سودوموناس آئروجینوزا (ATCC 27853) از مرکز ملی ذخایر ژنتیکی و زیستی ایران خریداری گردید.
نمونه برداری کرم خاکی L. rubellus و خالصسازی باکتریهای برون همزیست آن: نمونههای کرم خاکی L. rubellus(50 نمونه از عمق 5-15 سانتیمتری) از خاک مرطوب زمینهای کشاورزی اطراف خرمآباد جمعآوری گردید. به منظور حذف آلودگیهای ناخواسته، ابتدا کرمها با استفاده از آب مقطر استریل شستشو داده شدند. سپس به منظور جداسازی باکتریهای برون همزیست، با استفاده از سواپ استریل از سطح پوست L. rubellus نمونهگیری به عمل آمد. این سواپ میکروبی کاملاً در آب مقطر استریل تخلیه شد و از سوسپانسیون میکروبی حاصل، رقتهای سریالی از 1-10 تا 10-10 تهیه و 0/1 میلیلیتر از هر رقت بر روی محیط نوترینت آگار کشت داده شد (با کمک میله شیشهای سر کج دریگالسکی). پلیتها در دمای 35 درجه سانتیگراد به مدت 48 ساعت انکوبه شده و پس از آن کلنیها مختلف با استفاده از روش کشت خطی و بر روی محیط نوترینت آگار، خالصسازی شدند (10).
گزینش باکتریهای برون همزیست مهارکنندهی رشد باکتریهای بیماریزا: از کلنیهای تک حاصل از مرحله قبل، برای بررسی فعالیت ضد میکروبی سویههای جدا شده، از طریق روش انتشار در حفره آگار، علیه سویههای باکتریایی استاندارد باسیلوس سوبتیلیس، استافیلوکوکوس اورئوس، اشریشیاکلی و سودوموناس آئروجینوزا استفاده شد. برای این منظور، ابتدا از باکتریهای استاندارد و بر روی محیط نوترینت آگار کشت چمنی تهیه شد و مقداری از کلنی هر جدایه به آن اضافه گردید. ایجاد هاله عدم رشد در اطراف کشت خطی هر باکتری، فعالیت ضد میکروبی علیه آن درنظر گرفته شد. به منظور شناسایی دقیق بهترین جدایه انتخاب شده بر اساس هاله عدم رشد، از روشهای مورفولوژیکی، بیوشیمیایی و فیلوژنتیکی استفاده شد (10).
تجزیه و تحلیل فیلوژنتیکی: به منظور تکثیر ژن 16S rRNA، استخراج DNA ژنومی با استفاده از کیت High pure PCR Product (Roche، آلمان) صورت گرفت. به طور خلاصه، قبل از شروع خالصسازی، بافر شستشو تا 70 درجه سانتیگراد گرم شد و مراحل زیر به ترتیب انجام گرفت. به یک میکروتیوب 1/5 میلیلیتری فاقد نوکلئاز، 200 میکرولیتر از سوسپانسیون باکتریایی، 200 میکرولیتر بافر اتصال و 40 میکرولیتر پروتئیناز K اضافه شد. بلافاصله این مخلوط میکس شد و در دمای 70 درجه سانتیگراد به مدت 10 دقیقه انکوبه گردید. 100 میکرولیتر ایزوپروپانول اضافه و پس از اختلاط به مدت 1 دقیقه در دور g ×8000 سانتریفیوژ گردید. در ادامه 500 میکرولیتر بافر حذف و مهارکننده اضافه گردید و سانتریفیوژ انجام شد (1 دقیقه در دور g ×8000). سپس 500 میکرولیتر بافر شستشو اضافه و سانتریفیوژ تکرار گردید. نهایتا میکروتیوب حاوی DNA خالص در یخچال نگهداری شد. تکثیر ژن 16S rRNA طبق پروتکل استاندارد انجام گرفت. ژن 16S rRNA با استفاده از پرایمرهای F27 (5'AGAGTTTGATCMTGGCTCAG-3') و R1492 (5'TACGGYTACCTTGTTA CGACTT-3') تکثیر شد. واکنش زنجیرهای پلیمراز با حجم نهایی 25 میکرولیتر حاوی؛ 1 میکرولیتر DNAی الگو، 0/25 میکرولیتر از هر پرایمر، 5/5 میکرولیتر مسترمیکس و 18 میکرولیتر dd H2O، تحت برنامه دمایی- زمانی؛ دناتوراسیون اولیه: 94 درجه سانتیگراد 2 دقیقه، دناتوراسیون: 94 درجه سانتیگراد 45 ثانیه، آنیلینگ: 62 درجه سانتیگراد 45 ثانیه، تکثیر: 72 درجه سانتیگراد 2 دقیقه انجام شد. متعاقبا محصول نهایی واکنش روی ژل آگارز 1 درصد الکتروفورز شد. رنگآمیزی با ژل رد صورت گرفت و آشکارسازی با استفاده از ترانسلومیناتور (Biostep, Germany) انجام شد (11). در ادامه، محصول واکنش PCR توسط دستگاه توالی یابABI 377 (Applied Biosystems, Foster City, USA) با روش Sanger dideoxy sequencing تعیین توالی شد. برای تعیین میزان قرابت باکتری مورد مطالعه با دیگر باکتریها، BLAST توالی بهدست آمده در سایتNCBI (https://blast. ncbi. nlm. nih. gov/Blast. cgi) ، انجام گرفت. در نهایت درخت فیلوژنتیکی با استفاده از روش Neighbor-joining و با Bootstrap value of 1000 replications در نرمافزار MEGA (version 11) ترسم گردید.
تجزیه و تحلیل تکمیلی مورفولوژیکی و بیوشیمیایی: از آنجائیکه نتایج BLAST باکتری مورد نظر، میزان شباهت 98/66 درصدی را به باکتری Peribacillus butanolivorans نشان داد، به منظور اطمینان خاطر از تعیین دقیق گونه مربوطه، تجزیه و تحلیلهای تکمیلی مورفولوژیکی و بیوشیمیایی برای جدایه انجام شد.
رنگآمیزی اسپور به روش وارتز-کانکلین: از سوسپانسیون میکروبی گستره تهیه شد و لام با محلول مالاشیت سبز 0/5 درصد پوشانیده شد و به مدت 5 دقیقه با استفاده از شعله تحت حرارت قرار گرفت. سپس لام شستشو گردید و رنگآمیزی زمینه با استفاده از سافرانین 0/5 درصد به مدت 30 ثانیه صورت گرفت (12).
تست کاتالاز: مقداری از کلنی باکتری به یک لام تمیز منتقل شد و حدود 0/5 میلیلیتر از هیدروژن پروکسید 3 درصد به آن اضافه گردید. تشکیل حباب گاز مثبت بودن تست کاتالاز را نشان داد. از باکتری استرپتوکوکوس پایوژنز بهعنوان کنترل منفی استفاده شد (13).
تست اکسیداز: ارگانیزمهای دارای سیتوکروم C، آنزیم سیتوکروم اکسیداز تولید میکنند. این آنزیم در حضور اکسیژن اتمسفر، یک معرف احیاء بنام Ń-tetramethyl-p-phenylene diamine dihydrochloride (NTPDD) را اکسید کرده و ترکیب ایندوفنول به رنگ ارغوانی تیره بهوجود میآورد. جهت انجام این تست، یک کاغذ فیلتر به معرف احیاءŃ-tetramethyl-p-phenylene diamine dihydrochloride (NTPDD) آغشته شد و اجازه داده شد تا کاملاً خشک گردد. سپس مقداری از کلنی باکتری روی کاغذ قرار داده شد. تشکیل رنگ ارغوانی مثبت بودن تست در نظر گرفته شد. از باکتری استرپتوکوکوس پایوژنز بهعنوان کنترل منفی استفاده شد (14).
تست حرکت با روش قطره معلق در لام حفرهدار: برای این منظور، مقدار کمی وازلین در چهار گوشه لامل قرار داده شد و به اندازه 2 لوپ از نمونه مایع حاوی باکتری مورد آزمایش در وسط سطح لامل قرار داده شد. سپس لام در برابر سطح حاوی وازلین قرار گرفت و تحت فشار و به سرعت بر عکس گردید و در زیر میکروسکوپ نوری حرکت باکتری مورد بررسی قرار گرفت (15).
تست احیا نیترات به نیتریت، دنیتریفیکاسیون و نیتریفیکاسیون: برای انجام تست احیای نیترات به نیتریت و دنیتریفیکاسیون، محیط کشتهای A (5 گرم پپتون + 3 گرم عصاره مخمر + 10 گرم نیترات پتاسیم در 1000 میلیلیتر آب مقطر) و B (5 گرم پپتون + 3 گرم عصاره مخمر + 10 گرم نیتریت پتاسیم در 1000 میلیلیتر آب مقطر) همراه با لوله دورهام جهت پی بردن به تولید گاز حاصل از دنیتریفیکاسیون استفاده شد. جهت بررسی تست نیتریفیکاسیون از محیط استات براث (دارای آمونیوم کلراید بهعنوان تنها منبع نیتروژن) استفاده شد و تشکیل رنگ قرمز بدنبال استفاده از محلولهای α- نفتیل آمین و سولفانیلیک اسید، انجام نیتریفیکاسیون در نظر گرفته شد (16).
تست ایندول: برای این منظور مقداری باکتری به محیط غنی از تریپتوفان پپتون براث تلقیح شد و در دمای 35 درجه سانتیگراد به مدت 24 تا 48 ساعت انکوبه گردید. پس از ایجاد کدورت، 3 میلیلیتر از آن با 1 میلیلیتر گزیلن مخلوط شد تا ایندول از فاز آبی وارد فاز گزیلن گردد، سپس 0/5 میلیلیتر معرف کوآکس اضافه شد. ایجاد رنگ صورتی تا قرمز حاکی از مثبت بودن تست ایندول در نظر قرار گرفت. از باکتری اشریشیاکلی بهعنوان کنترل مثبت استفاده شد (16).
تست اوره آز: جهت انجام تست اوره آز، محیط اوره آگار بهصورت اسلنت تهیه شد و بهصورت سطحی و عمقی جدایه روی آن کشت داده شد و سپس در دمای 35 درجه سانتیگراد به مدت 18 تا 24 ساعت انکوبه گردید. رنگ محیط صورتی- قرمز مثبت بودن تست اوره آز را نشان داد. از باکتری پروتئوس میرابیلیس به عنوان باکتری کنترل مثبت استفاده شد (16).
تست مصرف سیترات: محیط سیمون سیترات را بهصورت اسلنت تهیه شد و باکتری بهطور سطحی و عمقی بر روی آن کشت داده شد. تولید رنگ آبی نشان دهنده مصرف سیترات توسط باکتری در نظر گرفته شد. از باکتری اشریشیاکلی بهعنوان باکتری شاهد منفی استفاده شد (16).
تست هیدرولیز ژلاتین: باکتری به محیط ژلاتین در لوله آزمایش تلقیح شد و در دمای 35 درجه سانتیگراد به مدت 2 روز انکوبه گردید. پس از گذشت 24 و 48 ساعت، لولهها در دمای 4 درجه سانتیگراد قرار داده شد. مایع ماندن محیط ژلاتین، مثبت بودن تست هیدرولیز ژلاتین را نشان داد. از باکتری اشریشیاکلی بهعنوان کنترل منفی استفاده شد (16).
تستOxidative Fermentative (OF) : استفاده از محیط اکسیداتیو- فرمانتاتیو (OF) یک روش ساده در تمایز بین مصرف هوازی و بیهوازی کربوهیدرات توسط میکروارگانیزمها است. در این تست از قند گلوکز استفاده گردید و 2 لوله O و F در نظر گرفته شد. با استفاده از آنس، باکتریها تا عمق لولهها تلقیح شدند و سپس در لوله F به میزان 2 میلیلیتر پارافین ریخته شد. همینطور 2 لوله O و F شاهد، بدون تلقیح باکتری در نظر گرفته شد و تمام لولهها در دمای 35 درجه سانتیگراد برای 14 روز انکوبه شدند. تولید اسید ناشی از مصرف قند از طریق تغییر رنگ معرف بروموتیمول بلو از سبز به زرد همراه است. تولید اسید در لوله O نشان دهنده واکنش اکسیداتیو و تولید اسید در هر دو لوله O و F نشان دهنده واکنش فرمانتاتیو بود. ترکیب محیط OF بر حسب 100 میلیلیتر آب مقطر شامل 2 گرم پپتون، 5 گرم سدیم کلراید، 0/3 گرم دیپتاسیم فسفات، 0/03 گرم بروموتیمول بلو، 2/5 گرم آگار و 1 گرم از قند مورد آزمایش بود. بعد از تهیه محیط OF، pH محیط بر روی 7/1 تنظیم شد که در این حالت رنگ محیط سبز خواهد شد (16).
تست بیهوازی: جهت انجام این تست، حدود 75 درصد از یک لوله آزمایش درب پیچدار با محیط کشت (5 گرم پپتون + 3 گرم عصاره مخمر در 1000 میلیلیتر آب مقطر) پر شد و بعد از استریل کردن، باکتری به آن تلقیح گردید. سپس مابقی فضای خالی لوله توسط محیط کشت استریل پر شد. درب لوله بسته شد و ظرف مدت 7 روز در دمای 35 درجه سانتیگراد انکوبه گردید و روزانه کدورت محیط جهت رشد باکتری بررسی شد (17).
تست مصرف منبع کربن جهت رشد: جهت بررسی مصرف منبع کربن توسط باکتری، در لولههای آزمایش مقادیر 1 درصد از منابع کربن مختلف گلوکز، مالتوز، گالاکتوز، لاکتوز، ساکارز، ریبوز، سوربیتول، L-آرابینوز، مانوز، رافینوز، D-زایلوز، مانیتول، تریپتوفان، نشاسته و سلوبیوز بهطور جداگانه به ازای 100 میلیلیتر محیط سنتزی (فاقد گلوکز) اضافه شد. پس از استریل کردن، باکتری به این محیطها تلقیح شد و لولههای آزمایش در دمای 35 درجه سانتیگراد انکوبه شدند. ایجاد کدورت در این محیطها نشان دهنده رشد باکتری بود (18).
تجزیه و تحلیل آماری
آنالیزهای آماری با استفاده از نرمافزار SPSS version 16 انجام شد. نتایج مربوط به شناسایی توالی نوکئوتیدی سویههای جداسازی شده نیز در پایگاه NCBI ثبت و آنالیز همولوژی ترادف انجام گرفت.
نتایج
جداسازی و خالصسازی باکتریها از کرم خاکیL. rubellus : بر اساس اندازه، رنگ، قوام و شکل کلنیهای رشد یافته بر روی محیط نوترینت آگار، تعداد 14 کلنی متفاوت تشخیص داده شد (شکل1). این کلنیها با استفاده از روش کشت خطی و بر روی محیط نوترینت آگار، از هم تفکیک و خالصسازی و به ترتیب از L1 تا L14 شماره گذاری شدند.
نتایج گزینش باکتریهای تولید کننده ماده ضد میکروبی: باکتریهای تولید کننده ماده ضد باکتریایی از طریق ایجاد هاله عدم رشد گزینش شدند. نتایج نشان داد که از بین 14 کلنی تخلیص شده، 3 جدایه (L1، L4 و L7) قادر به تولید هاله عدم رشد بودند که از این میان تنها جدایه L4 توانست در برابر هر چهار باکتری مورد مطالعه هاله عدم رشد تولید کند (جدول1). از آنجا که هدف ما گزینش یک باکتری با بیشترین دامنه تاثیر بر روی باکتریهای مورد مطالعه بود، بنابراین جدایه L4 برای مطالعات بعدی انتخاب گردید.
نتایج شناسایی فیلوژنتیکی باکتری ایزوله شده: پس از استخراج DNA باکتری و انجام PCR جهت تکثیر قطعه 16 SrDNA، محصول PCR بر روی ژل آگارز 1 درصد الکتروفورز شد. در نتیجه آن یک باند در نزدیکی محلbp 1500 در مقایسه با مارکر kb 2 مشاهده شد که حاکی از صحت انجام واکنش تکثیر 16 SrDNA بود (شکل2). با تعیین توالی محصول PCR، 1448 جفت باز نوکلئوتید بهدست آمد که توالی آنها در شکل3 نشان داده شده است. نتایج همانندجویی بهدست آمده با کمک نرمافزار BLAST در NCBI نیز نشان داد که این توالی، 98/96 درصد به توالی نوکلئوتیدی باکتری Peribacillus butanolivorans strain NECC10521 و 98/62 درصد به توالی نوکلئوتیدی باکتریهای Bacillus simplex strain QT421، Bacillus sp. (in: Bacteria) strain SQ7-2 وPeribacillus simplex strain JX7-qm شباهت دارد. در مورد توالی چند گونه از جنسهای Peribacillus وBacillus و در رتبههای بعدی میزان شباهت به 55/98 درصد تقلیل یافت. برای مقایسه بیشتر، نتایج همولوژی و بلاست در سایت NCBI در (جدول2) آورده شده است. همولوژی بهدست آمده با کمک نرمافزار BLAST در NCBI، قرابت باکتری مورد مطالعه را با سایر باکتریها مشخص نمود (جدول2). بر این اساس، درخت فیلوژنتیکی با استفاده از روش Neighbor joining رسم شد که در شکل4 نشان داده شده است. بررسیهای فیلوژنتیکی نشان داد که جدایه L4 دستهای (خوشه) را با سویههای مختلف P. butanolivorans تشکیل میدهد و در این میان بیشترین قرابت را به سویهی SMV514-R2L31 نمایان میسازد. البته این در حالی است که سویهی KG با سایر سویههای این گونه یعنی سویه¬های C2L5D، C2L5C و JN3109 قرابت بسیار زیادی دارد. اما گونه دیگر جنس Bacillus یعنی B. subtilis بهعنوان outliers دستهبندی شد که این امر تاییدی بر تعلق KG به گونه P. butanolivorans بود. همچنان که در این شکل مشخص است، سایر جنسهای باکتریایی یا قارچی نیز هر کدام دستههای جداگانه و دوری را با جدایه KG تشکیل دادند (شکل4). مقادیر Bootstrap بهصورت درصدهایی از 1,000 replications نشان داده شدهاند. مقیاس مورد استفاده، 0/001 جایگزینی به ازای موقعیت هر نوکلئوتید را نشان میدهد.

شکل 1: کلنیهای رشد کرده بر روی محیط نوترینت آگار جدا شده از L. rubellus
جدول 1: قابلیت تولید هاله عدم رشد توسط جدایهها (باکتریهای برون همزیست) علیه باکتریهای مورد مطالعه


شکل 2: (راست) باند 16S rDNA حاصل از PCR با استفاده از الکتروفورز با ژل آگارز 1 درصد؛ (چپ) نمایی از مارکر بهکار گرفته شده در این الکتروفورز

شکل 3: نتایج تعیین توالی S rDNA16 باکتری جداسازی شده
جدول2: نتایج حاصل از بررسی همولوژی توالی ژن 16S rDNAی باکتری ایزوله شده در NCBI



شکل 4: ارتباط فیلوژنتیکی بر اساس توالی ژن 16S rRNA، بین سویه KG و گونههای جنس Peribacillus بر پایه روش Neighbor-joining

شکل 5: نمایی از پلیت حاوی باکتری P. butanolivorans KG بر روی محیط نوترینت آگار
نتایج تستهای تکمیلیمورفولوژیکی و بیوشیمیایی: بهمنظور شناسایی دقیقتر سویه برگزیده، تستهای تکمیلی مورفولوژی و بیوشیمیایی مختلفی بر روی آن انجام گرفت که در ادامه به آنها پرداخته میشود. در شکل5، شکل کلنی این باکتری نشان داده شده است. همانگونه که در شکل مشخص است، باکتری دارای کلنی کرمی رنگ، دایرهای با حاشیه صاف بود.
رنگآمیزی جدایه: نتایج رنگآمیزی گرم در شکل6 نشان داده شده است. همانگونه که در شکل مشخص است، باکتری به رنگ آبی- بنفش (گرم مثبت) و به شکل باسیلی، زنجیرهای و پراکنده دیده شد.
نتایج رنگآمیزی اسپور به روش وارتز-کانکلین: همانطور که در شکل7 نشان داده شده است، نتایج رنگآمیزی اسپور به روش وارتز- کانکلین باکتریهایی قرمز رنگ دارای نقاط سبز رنگ را نشان داد که مبنی بر توانایی باکتری در تولید اسپور بود.
نتایج تست کاتالاز: نتایج تست کاتالاز در شکل 8 نشان داده شده است. همچنانکه در سمت چپ تصویر مشخص است، باکتری مورد مطالعه ما قادر به تولید حباب بوده و بنابراین کاتالاز مثبت است، در حالی که باکتری استرپتوکوکوس پایوژنز در سمت راست تصویر، بهعنوان کنترل قادر به تولید حباب نبود.
نتایج تست اکسیداز: نتایج تست اکسیداز در شکل9 نشان داده شده است. همانطور که در این شکل مشخص است، باکتری P. butanolivorans KG (سمت راست) توانسته است معرف NTPDD را اکسید کرده و ترکیب ایندوفنول به رنگ ارغوانی تیره بوجود آورد که به معنی اکسیداز مثبت بودن آن میباشد. در حالی که باکتری استرپتوکوکوس پایوژنز در سمت چپ تصویر، بهعنوان کنترل قادر به تولید رنگ ارغوانی نبوده است.
نتایج تست حرکت با روش قطره معلق در لام حفرهدار: مشاهدات انجام گرفته در زیر میکروسکوپ نوری در مورد قدرت حرکت باکتری P. butanolivorans KG با استفاده از روش قطره معلق در لام حفرهدار، نشان داد که این باکتری متحرک میباشد.
نتایج تست احیا نیترات به نیتریت، دنیتریفیکاسیون و نیتریفیکاسیون: نتایج تست احیا نیترات به نیتریت توسط باکتری P. butanolivorans KGنشان داد که این باکتری توانسته رنگ دیازونیوم قرمز را بهوجود آورد و لوله آزمایش حاوی محیط استات براث (دارای آمونیوم کلراید بهعنوان تنها منبع نیتروژن) را قرمز رنگ نماید، بنابراین قادر به احیاء نیترات به نیتریت بوده است (شکل10). لازم به ذکر است که باکتری مورد مطالعه قادر به دنیتریفیکاسیون و نیتریفیکاسیون نبود.
نتایج تست ایندول: همانطور که در (شکل11) (سمت راست) نشان داده شده، باکتری P. butanolivorans KG قادر به هیدرولیز اسید آمینه تریپتوفان نبوده و در نتیجه حلقه ایندول تولید نکرده است. بر عکس، در لوله سمت چپ، باکتری اشریشیاکلی حلقه ایندول تولید کرده است که نشان دهنده صحت روش انجام تست می¬باشد. بنابراین باکتری مورد مطالعه ایندول منفی میباشد.
نتایج تست اوره آز: نتایج تست تجزیه اوره در (شکل12) نشان داده شده است. همچنانکه در این شکل مشخص است، باکتری P. butanolivorans KG (سمت چپ تصویر) قادر به تجزیه اوره و در نتیجه تولید رنگ ارغوانی در محیط اوره نبوده است، اما باکتری پروتئوس میرابیلیس (سمت راست تصویر)؛ با تجزیه اوره باعث تغییر رنگ لوله آزمایش به ارغوانی شده است. بنابراین باکتری مورد مطالعه اوره منفی می باشد.
نتایج تست مصرف سیترات: نتیجه این تست توانایی باکتری P. butanolivorans KG در مصرف سیترات بهعنوان تنها منبع کربن موجود در محیط مورد استفاده را در (شکل13) نشان می دهد. همانطور که قابل ملاحظه است، این باکتری (سمت چپ تصویر) با مصرف سیترات باعث تغییر pH و در نتیجه تغییر رنگ محیط از سبز به آبی شده و بنابراین سیترات مثبت است. باکتری اشریشیا کلی (سمت راست تصویر) که بهعنوان شاهد منفی استفاده شده بود قادر به مصرف سیترات نبوده و بنابراین تغییری در رنگ محیط کشت ایجاد نکرده است.
نتایج تست هیدرولیز ژلاتین: نتایج تست هیدرولیز ژلاتین در شکل14 نشان میدهد که باکتری P. butanolivorans KG (تصویر پایین) توانسته است با هیدرولیز ژلاتین باعث سیالیت بیشتر محیط شود و بنابراین ژلاتین مثبت است. اما باکتری اشریشیا کلی (تصویر بالا) بهعنوان کنترل قادر به هیدرولیز ژلاتین نبود.
نتایج تست Oxidative Fermentative (OF) : بر اساس نتایجی که از این تست بدست آمد، مشخص شد که باکتری P. butanolivorans KG در شرایط هوازی (اکسیداتیو) قادر به مصرف گلوکز بوده و بنابراین با تولید متابولیت های اسیدی، باعث تغییر رنگ محیط از سبز به زرد میشود اما در شرایط بیهوازی قادر به تخمیر گلوکز نمی باشد (شکل15).
نتایج تست بی هوازی: بررسیهای انجام گرفته در طی 7 روز نشان داد که باکتری P. butanolivorans KG در محیط کشت حاوی 5 گرم پپتون بعلاوه 3 گرم عصاره مخمر در 1000 میلیلیتر آب مقطر و در شرایط بی هوازی، قادر به رشد نمی باشد.
نتایج تست مصرف منبع کربن جهت رشد: نتایج بررسی رشد و تولید کدورت با منابع مختلف کربنی توسط باکتری P. butanolivorans KG نشان داد که این باکتری قدرت استفاده از منابع کربنی کازئین، مالتوز، گالاکتوز، لاکتوز، ساکارز، ریبوز، سوربیتول، مانوز، L- آرابینوز، مانیتول، رافینوز، نشاسته، سلوبیوز و تریپتوفان را، بهعنوان منابع کربنی نداشت اما قادر بود گلوکز و ژلاتین را هیدرولیز کند. بهطورکلی نتایج تستهای مورفولوژیکی و بیوشیمیایی باکتری مورد مطالعه در (جدول3) خلاصه شده است. در نهایت، بر اساس نتایج بهدست آمده از بررسی های فیلوژنتیکی و تستهای تکمیلی مورفولوژیکی و بیوشیمیایی، سویه مورد مطالعه تحت عنوان Peribacillus butanolivorans KG شناسایی و نام-گذاری گردید. این باکتری در پایگاه داده GenBank با شماره دسترسی OR229899. 1 ثبت شد و در دسترس سایرین قرار گرفت.

شکل 6: نمایی از رنگآمیزی گرم در زیر میکروسکوپ

شکل 7: نمایی از رنگآمیزی اسپور به روش وارتز- کانکلین که در آن اسپورها بهصورت نقاط سبز رنگ در درون باکتریهای قرمز رنگ دیده میشوند

شکل 8: نمایی از نتایج تست کاتالاز. سمت راست: استرپتوکوکوس پایوژنز (کاتالاز منفی) و سمت چپ: P. butanolivorans KG (کاتالاز مثبت)

شکل 9: نمایی از نتایج تست اکسیداز. سمت راست: P. butanolivorans KG (اکسیداز مثبت) و سمت چپ: استرپتوکوکوس پایوژنز (اکسیداز منفی)

شکل 10: نمایی از تست احیاء نیترات به نیتریت که در آن باکتری P. butanolivorans KG توانسته رنگ دیازونیوم قرمز را بهوجود آورد (سمت چپ تصویر) و بنابراین قادر به احیاء نیترات به نیتریت بوده است

شکل 11: نتیجه تست ایندول که در آن باکتری P. butanolivorans KG (سمت راست تصویر) ایندول منفی و باکتری اشریشیاکلی (سمت چپ تصویر) ایندول مثبت است

شکل 12: نمایی تست اوره آز که در آن باکتری P. butanolivorans KG (سمت چپ) اوره آز منفی و باکتری پروتئوس میرابیلیس (سمت راست تصویر) اورهآز مثبت بود

شکل 13: نتایج تست مصرف سیترات که در آن باکتری P. butanolivorans KG (سمت چپ تصویر)، سیترات مثبت و باکتری اشریشیاکلی (سمت راست تصویر) سیترات منفی است

شکل 14: نتایج تست هیدرولیز ژلاتین که در آن باکتری P. butanolivorans KG (تصویر پایین) ژلاتین مثبت بوده و محیط را به فرم مایع در آورد اما باکتری اشریشیاکلی (تصویر بالا) چنینی قابلیتی را نشان نداد

شکل 15: نتایج تست مصرف گلوکز توسط باکتری P. butanolivorans KG. سمت راست (اکسیداتیو) و سمت چپ (تخمیری)
جدول3: مقایسه نتایج تستهای مورفولوژیکی و بیوشیمیایی باکتری مورد مطالعه با سایر باکتریهای مشابه


بحث
این مطالعه با هدف شناسایی باکتریهای برون همزیست کرم خاکی L. rubellus بهعنوان مهارکنندههای رشد برخی از باکتریهای بیماریزا انجام شد. اکثر محققان نتایج امیدوارکنندهای را برای کرم خاکی L. rubellus و درون همزیستهای آن بهعنوان یک عامل ضد میکروبی از بررسی متون گزارش کردهاند. با اینحال، هنوز مطالعات پتانسیل باکتریهای برون همزیست آن بهعنوان مهارکنندههای رشد باکتریهای بیماریزا را پشتیبانی نمیکنند. مقاومت آنتیبیوتیکی یک چالش مداوم بوده است که تقریباً بلافاصله پس از کشف اولیه آنتیبیوتیکها پدیدار شده است و نیاز به توسعه آنتیبیوتیکهای جدید و ترکیبات آنتیبیوتیکی نوآورانهای وجود دارد که بتوانند بهطور مؤثر توسعه مقاومت را کاهش دهند. سالانه بیش از 35000 نفر تنها در ایالات متحده بر اثر عفونتهای مقاوم به آنتیبیوتیک جان خود را از دست میدهند. این امر اهمیت شناسایی جایگزینهای دیگر برای آنتیبیوتیکهایی که مقاومت در برابر آنها ایجاد شده است را نشان میدهد. تقریباً میتوان منشأ همه آنتیبیوتیکهای مورد استفاده فعلی را در باکتریها و قارچهای مشتق شده از خاک ردیابی کرد. باکتریها و قارچهای دخیل در همزیستی، حوزهای است که هنوز برای کشف و توسعه آنتیبیوتیکهای جدید به طور گسترده ناشناخته مانده است (1،19). سیستم همزیستی کرم خاکی یکی از بهترین همزیستیهای دفاعی مورد مطالعه تا به امروز را شامل میشود. بهطور خاص، باکتریهای همزیست کرم خاکی، بینش شگفتانگیزی در مورد مجموعهای از ذرات زیست فعال که توسط بیمهرگان بهکار گرفته میشوند، ارائه دادهاند که نهتنها به برآورده کردن نیازهای غذایی و تولیدمثلی میزبان کمک میکند، بلکه میزبان را قادر میسازد تا در برابر شکارچیان احتمالی، بهویژه حشرات مختلف، دفاع نماید. برخی از این همزیستهای باکتریایی در میزبانهای متعدد شناخته شدهاند، اما بهنظر میرسد اکثر سویهها مختص گونه هستند (20-22). مدتهاست که از کرم خاکی L. rubellus بهعنوان دارو برای درمان انواع بیماریها و بهبود سیستم ایمنی استفاده میشود. عصاره L. rubellus دارای خواص ضد باکتریایی است و میتواند باکتریهای گرم مثبت و گرم منفی را مهار نماید (23،24). L. rubellus دارای یک پپتید ضد میکروبی بهنام لومبریسین 1 است که نقش حیاتی در دفاع طبیعی در برابر میکروبهای بیماریزا ایفا میکند. این پپتید منجر به ایجاد منافذ در دیواره سلولی باکتری میشود. این امر باعث میشود که سیتوپلاسم سلولهای باکتریایی در معرض محیط بیرون قرار گیرد و مرگ باکتری را بهدنبال داشته باشد (25). مطالعات متعددی استفاده از عصاره L. rubellus بهعنوان یک داروی جایگزین برای درمان بیماریهای عفونی مانند تب حصبه (26)، عفونت پریآپیکال (27) و پریودنتیت (28) را گزارش داده¬اند. امروزه نه تنها کرم خاکی L. rubellus، بلکه باکتریهای همزیست L. rubellus دارای فعالیتهای آنتیبیوتیکی نیز بهعنوان دارو استفاده میشوند. باکتریهای برونهمزیست میتوانند نقش مهمی در دفاع از میزبان خود در برابر عوامل بیماریزا ایفا کنند. این باکتریها که روی سطح L. rubellus زندگی میکنند، میتوانند با رقابت با عوامل بیماریزا برای منابع، تولید مواد ضدمیکروبی یا حتی تأثیرگذاری بر پاسخ ایمنی میزبان، از او محافظت کنند (9). بنابراین، غربالگری بیشتر باکتریهای برون همزیست بالقوه کرم L. rubellus. ضرورت دارد. بر اساس مشاهدات فعالیت بازدارندگی، سنجش ما نشان داد که Peribacillus butanolivorans KG جدا شده از باکتریهای برون همزیست کرم خاکی L. rubellus قادر به مهار رشد چهار باکتری بیماریزا شامل باسیلوس سوبتیلیس، استافیلوکوکوس اورئوس، اشریشیاکلی و سودوموناس آئروجینوز بود. بر این اساس میتوان بیان داشت که باکتری Peribacillus butanolivorans KG احتمالا متابولیتی را تولید میکند که قادر به مهار رشد باکتریهای بیماریزا میباشد. این با مطالعه Fiolka و همکاران مطابقت دارد که نشان دادهاند یک باکتری درون همزیست جدا شده از روده میانی کرم خاکی دارای فعالیت ضد مایکوباکتریایی است و فعالیتی را در برابر چهار سویه از مایکوباکتریهای سریع الرشد نشان میدهد (29). در مطالعات دیگری نیز، دو جدایه باکتریایی از کرم Pheretima sp. به نامهای Bacillus choshinensis و Bacillus brevis با خاصیت ضد میکروبی گزارش شده است (30،31).
بر اساس نتایج مطالعه حاضر، از جداسازی Peribacillus butanolivorans KG جدا شده از باکتریهای برون همزیست کرم خاکی L. rubellus، میتوان نتیجه گرفت که Peribacillus butanolivorans KG بهطور مؤثر رشد باکتریهای باسیلوس سوبتیلیس، استافیلوکوکوس اورئوس، اشریشیا کلی و سودوموناس آئروجینوز را مهار میکند و احتمالا پتانسیل عمل بهعنوان آنتیبیوتیک را دارد. علاوه بر این، آنالیز ماهیت متابولیتهای تولیدی Peribacillus butanolivorans KG و انجام مطالعات بیشتر برای بررسی مکانیسمهای مهاری Peribacillus butanolivorans KG علیه باکتریهای بیماریزا توصیه میشود.
نتیجه گیری
نتیجه میگیریم که گونه Peribacillus butanolivorans KG جدا شده از باکتریهای برون همزیست کرم خاکی L. rubellus، با تولید متابولیتی دارای فعالیتهای ضد باکتریایی است و این یافتهها میتواند بهعنوان مبنایی برای جلوگیری از ظهور مقاومت چند دارویی و تولید عوامل ضد باکتریایی مبتنی بر محصولات طبیعی مورد استفاده قرار گیرند.
سپاسگزاری
این مقاله حاصل پایاننامه تحت عنوان "جداسازی باکتری مولد ترکیبات آنتی باکتریال از کرم خاکی (Lumbricus rubellus)" در مقطع کارشناسی ارشد در سال 1402 دانشگاه آزاد اسلامی واحد خرم آباد میباشد که با حمایت دانشگاه آزاد اسلامی واحد خرم آباد انجام شده است.
ملاحظات اخلاقی
پروپوزال این تحقیق توسط کمیته ملی اخلاق در پژوهشهای زیست پزشکی دانشگاه آزاد اسلامی تایید شده است (کد اخلاق: IR.IAU.SHK.REC.1403.025).
مشارکت نویسندگان
فرهاد گیلاوند در ارائه ایده، فرهاد گیلاوند، امیر ارسلان کاویانی فرد و بهروز دوستی در طراحی مطالعه، محمد بهرامینژاد در جمعآوری دادهها، محمد بهرامینژاد و نجمه مولوی وردنجانی در تجزیه و تحلیل دادهها مشارکت داشته و همه نویسندگان در تدوین، ویرایش اولیه و نهایی مقاله و پاسخگویی به سوالات مرتبط با مقاله سهیم هستند.
سازمان بهداشت جهانی در گزارشهای مختلف بر تهدید جهانی قریبالوقوع مقاومت آنتیبیوتیکی تأکید کرده است، بهطوریکه تا سال 2050، میزان مرگ و میر جهانی ناشی از پاتوژنهای مقاوم به آنتیبیوتیک میتواند سالانه به 10 میلیون نفر برسد (1،2). افزایش چشمگیر مقاومت پاتوژنها در برابر آنتیبیوتیکها در طول 60 سال گذشته بهعنوان یک چالش مداوم که عموما با جهش یا انتقال افقی ژن پدیدار میشود، همواره نیاز به توسعه آنتیبیوتیکهای جدید و ترکیبات آنتیبیوتیکی نوآورانه بهعنوان جایگزینهای مناسب برای آنتیبیوتیکهایی که مقاومت در برابر آنها ایجاد شده است را نشان میدهد (3). تقریباً میتوان منشأ همه آنتیبیوتیکهای مورد استفاده فعلی را در میکروارگانیسمهای مشتق شده از خاک ردیابی کرد که در این بین امیدوارکنندهترین فرصتها برای کشف و توسعه آنتیبیوتیکها، میکروارگانیسمهایی هستند که بهصورت همزیست با یک گیاه، جانور یا میکروارگانیسم دیگری در خاک زندگی میکنند (1). تکامل همزمان همزیستهای میکروبی با میزبانهای خاص خود منجر به بیان ویژگیهای بیوشیمیایی منحصربهفردی میشود که منابع غنی از متابولیتهای ثانویه با فعالیتهای زیستی قابلتوجه از نظر درمانی را فراهم میسازند (4). به عبارت دیگر، از منظر کشف دارو، در قلب سیستمهای همزیستی، محصولات طبیعی با ساختارهای متمایزی وجود دارد (5) که حداقل 40 درصد از این داربستهای شیمیایی توسط ترکیبات مصنوعی قابل فرآوری نیستند. از اینرو، این محصولات طبیعی به دلیل جهتگیریهای فضایی پیچیده و کاملاً تعریف شده خود که یک ساختار بیولوژیکی منحصربهفرد را ایجاد میکنند، نقاط شروع استثنایی در کشف دارو هستند (6). کرمهای خاکی مهمترین بیمهرگان خاک هستند و تاکنون برای بررسی عوامل درمانی بالقوه مورد استفاده قرار گرفتهاند، اگرچه باکتریهای دخیل در همزیستی آنها، حوزهای است که هنوز برای کشف و توسعه آنتیبیوتیکهای جدید بهطور گسترده ناشناخته مانده است، این در حالی است که مشخص شده است کرمهای خاکی بهعنوان حامل باکتریهای سالم خاک با خاصیت درمانی عمل میکنند (7). در میان کرمهای خاکی، Lumbricus rubellus (L. rubellus)، سابقه طولانی در استفاده دارویی بهعنوان درمان کمکی یا طب جایگزین دارد. کرم خاکی L. rubellus به گروه کرمهای خاکی اپیژئیک تعلق دارد که در ۵ سانتیمتر بالایی لایه خاک و در لایه بستر زندگی میکنند (8). از آنجاییکه لایه بستر خاک تنوع باکتریایی قابلتوجهی را در خود جای داده است، کرم خاکی L. rubellus از همزیستی متنوع باکتریایی برخوردار میباشد. اگر چه نقش درون همزیستهای L. rubellus در کشف آنتیبیوتیک بیشتر شناخته شده است، اما تنها مطالعات کمی در مورد پتانسیل ترکیبات تولید شده توسط باکتریهای برون همزیست آن بحث کردهاند، حال آنکه شواهد نشان میدهد باکتریهای برون همزیست بهطور خاص در دفاع از میزبان خود در برابر پاتوژنها نقش ایفا میکنند (9). بنابراین، غربالگری بیشتر باکتریهای برون همزیست بالقوه کرم L. rubellus، در راستای شناسایی اهداف درمانی ضد میکروبی ضرورت دارد. هدف از این مطالعه شناسایی باکتریهای برون همزیست کرم خاکی L. rubellus بهعنوان مهارکنندههای رشد برخی از باکتریهای بیماریزا است.
روش بررسی
این مطالعه پژوهشی بهصورت تجربی از اسفند ماه 1401 تا شهریور ماه 1402 در مرکز تحقیقات گیاهان دارویی مجتمع آزمایشگاهی رازی دانشگاه علوم پزشکی لرستان و آزمایشگاه تحقیقاتی دانشگاه آزاد اسلامی واحد خرمآباد انجام شد. باکتریهای مورد نظر تحقیق یعنی باسیلوس سوبتیلیس (ATCC 465)، استافیلوکوکوس اورئوس ((ATCC 25923، اشریشیا کلی (ATCC 25922) و سودوموناس آئروجینوزا (ATCC 27853) از مرکز ملی ذخایر ژنتیکی و زیستی ایران خریداری گردید.
نمونه برداری کرم خاکی L. rubellus و خالصسازی باکتریهای برون همزیست آن: نمونههای کرم خاکی L. rubellus(50 نمونه از عمق 5-15 سانتیمتری) از خاک مرطوب زمینهای کشاورزی اطراف خرمآباد جمعآوری گردید. به منظور حذف آلودگیهای ناخواسته، ابتدا کرمها با استفاده از آب مقطر استریل شستشو داده شدند. سپس به منظور جداسازی باکتریهای برون همزیست، با استفاده از سواپ استریل از سطح پوست L. rubellus نمونهگیری به عمل آمد. این سواپ میکروبی کاملاً در آب مقطر استریل تخلیه شد و از سوسپانسیون میکروبی حاصل، رقتهای سریالی از 1-10 تا 10-10 تهیه و 0/1 میلیلیتر از هر رقت بر روی محیط نوترینت آگار کشت داده شد (با کمک میله شیشهای سر کج دریگالسکی). پلیتها در دمای 35 درجه سانتیگراد به مدت 48 ساعت انکوبه شده و پس از آن کلنیها مختلف با استفاده از روش کشت خطی و بر روی محیط نوترینت آگار، خالصسازی شدند (10).
گزینش باکتریهای برون همزیست مهارکنندهی رشد باکتریهای بیماریزا: از کلنیهای تک حاصل از مرحله قبل، برای بررسی فعالیت ضد میکروبی سویههای جدا شده، از طریق روش انتشار در حفره آگار، علیه سویههای باکتریایی استاندارد باسیلوس سوبتیلیس، استافیلوکوکوس اورئوس، اشریشیاکلی و سودوموناس آئروجینوزا استفاده شد. برای این منظور، ابتدا از باکتریهای استاندارد و بر روی محیط نوترینت آگار کشت چمنی تهیه شد و مقداری از کلنی هر جدایه به آن اضافه گردید. ایجاد هاله عدم رشد در اطراف کشت خطی هر باکتری، فعالیت ضد میکروبی علیه آن درنظر گرفته شد. به منظور شناسایی دقیق بهترین جدایه انتخاب شده بر اساس هاله عدم رشد، از روشهای مورفولوژیکی، بیوشیمیایی و فیلوژنتیکی استفاده شد (10).
تجزیه و تحلیل فیلوژنتیکی: به منظور تکثیر ژن 16S rRNA، استخراج DNA ژنومی با استفاده از کیت High pure PCR Product (Roche، آلمان) صورت گرفت. به طور خلاصه، قبل از شروع خالصسازی، بافر شستشو تا 70 درجه سانتیگراد گرم شد و مراحل زیر به ترتیب انجام گرفت. به یک میکروتیوب 1/5 میلیلیتری فاقد نوکلئاز، 200 میکرولیتر از سوسپانسیون باکتریایی، 200 میکرولیتر بافر اتصال و 40 میکرولیتر پروتئیناز K اضافه شد. بلافاصله این مخلوط میکس شد و در دمای 70 درجه سانتیگراد به مدت 10 دقیقه انکوبه گردید. 100 میکرولیتر ایزوپروپانول اضافه و پس از اختلاط به مدت 1 دقیقه در دور g ×8000 سانتریفیوژ گردید. در ادامه 500 میکرولیتر بافر حذف و مهارکننده اضافه گردید و سانتریفیوژ انجام شد (1 دقیقه در دور g ×8000). سپس 500 میکرولیتر بافر شستشو اضافه و سانتریفیوژ تکرار گردید. نهایتا میکروتیوب حاوی DNA خالص در یخچال نگهداری شد. تکثیر ژن 16S rRNA طبق پروتکل استاندارد انجام گرفت. ژن 16S rRNA با استفاده از پرایمرهای F27 (5'AGAGTTTGATCMTGGCTCAG-3') و R1492 (5'TACGGYTACCTTGTTA CGACTT-3') تکثیر شد. واکنش زنجیرهای پلیمراز با حجم نهایی 25 میکرولیتر حاوی؛ 1 میکرولیتر DNAی الگو، 0/25 میکرولیتر از هر پرایمر، 5/5 میکرولیتر مسترمیکس و 18 میکرولیتر dd H2O، تحت برنامه دمایی- زمانی؛ دناتوراسیون اولیه: 94 درجه سانتیگراد 2 دقیقه، دناتوراسیون: 94 درجه سانتیگراد 45 ثانیه، آنیلینگ: 62 درجه سانتیگراد 45 ثانیه، تکثیر: 72 درجه سانتیگراد 2 دقیقه انجام شد. متعاقبا محصول نهایی واکنش روی ژل آگارز 1 درصد الکتروفورز شد. رنگآمیزی با ژل رد صورت گرفت و آشکارسازی با استفاده از ترانسلومیناتور (Biostep, Germany) انجام شد (11). در ادامه، محصول واکنش PCR توسط دستگاه توالی یابABI 377 (Applied Biosystems, Foster City, USA) با روش Sanger dideoxy sequencing تعیین توالی شد. برای تعیین میزان قرابت باکتری مورد مطالعه با دیگر باکتریها، BLAST توالی بهدست آمده در سایتNCBI (https://blast. ncbi. nlm. nih. gov/Blast. cgi) ، انجام گرفت. در نهایت درخت فیلوژنتیکی با استفاده از روش Neighbor-joining و با Bootstrap value of 1000 replications در نرمافزار MEGA (version 11) ترسم گردید.
تجزیه و تحلیل تکمیلی مورفولوژیکی و بیوشیمیایی: از آنجائیکه نتایج BLAST باکتری مورد نظر، میزان شباهت 98/66 درصدی را به باکتری Peribacillus butanolivorans نشان داد، به منظور اطمینان خاطر از تعیین دقیق گونه مربوطه، تجزیه و تحلیلهای تکمیلی مورفولوژیکی و بیوشیمیایی برای جدایه انجام شد.
رنگآمیزی اسپور به روش وارتز-کانکلین: از سوسپانسیون میکروبی گستره تهیه شد و لام با محلول مالاشیت سبز 0/5 درصد پوشانیده شد و به مدت 5 دقیقه با استفاده از شعله تحت حرارت قرار گرفت. سپس لام شستشو گردید و رنگآمیزی زمینه با استفاده از سافرانین 0/5 درصد به مدت 30 ثانیه صورت گرفت (12).
تست کاتالاز: مقداری از کلنی باکتری به یک لام تمیز منتقل شد و حدود 0/5 میلیلیتر از هیدروژن پروکسید 3 درصد به آن اضافه گردید. تشکیل حباب گاز مثبت بودن تست کاتالاز را نشان داد. از باکتری استرپتوکوکوس پایوژنز بهعنوان کنترل منفی استفاده شد (13).
تست اکسیداز: ارگانیزمهای دارای سیتوکروم C، آنزیم سیتوکروم اکسیداز تولید میکنند. این آنزیم در حضور اکسیژن اتمسفر، یک معرف احیاء بنام Ń-tetramethyl-p-phenylene diamine dihydrochloride (NTPDD) را اکسید کرده و ترکیب ایندوفنول به رنگ ارغوانی تیره بهوجود میآورد. جهت انجام این تست، یک کاغذ فیلتر به معرف احیاءŃ-tetramethyl-p-phenylene diamine dihydrochloride (NTPDD) آغشته شد و اجازه داده شد تا کاملاً خشک گردد. سپس مقداری از کلنی باکتری روی کاغذ قرار داده شد. تشکیل رنگ ارغوانی مثبت بودن تست در نظر گرفته شد. از باکتری استرپتوکوکوس پایوژنز بهعنوان کنترل منفی استفاده شد (14).
تست حرکت با روش قطره معلق در لام حفرهدار: برای این منظور، مقدار کمی وازلین در چهار گوشه لامل قرار داده شد و به اندازه 2 لوپ از نمونه مایع حاوی باکتری مورد آزمایش در وسط سطح لامل قرار داده شد. سپس لام در برابر سطح حاوی وازلین قرار گرفت و تحت فشار و به سرعت بر عکس گردید و در زیر میکروسکوپ نوری حرکت باکتری مورد بررسی قرار گرفت (15).
تست احیا نیترات به نیتریت، دنیتریفیکاسیون و نیتریفیکاسیون: برای انجام تست احیای نیترات به نیتریت و دنیتریفیکاسیون، محیط کشتهای A (5 گرم پپتون + 3 گرم عصاره مخمر + 10 گرم نیترات پتاسیم در 1000 میلیلیتر آب مقطر) و B (5 گرم پپتون + 3 گرم عصاره مخمر + 10 گرم نیتریت پتاسیم در 1000 میلیلیتر آب مقطر) همراه با لوله دورهام جهت پی بردن به تولید گاز حاصل از دنیتریفیکاسیون استفاده شد. جهت بررسی تست نیتریفیکاسیون از محیط استات براث (دارای آمونیوم کلراید بهعنوان تنها منبع نیتروژن) استفاده شد و تشکیل رنگ قرمز بدنبال استفاده از محلولهای α- نفتیل آمین و سولفانیلیک اسید، انجام نیتریفیکاسیون در نظر گرفته شد (16).
تست ایندول: برای این منظور مقداری باکتری به محیط غنی از تریپتوفان پپتون براث تلقیح شد و در دمای 35 درجه سانتیگراد به مدت 24 تا 48 ساعت انکوبه گردید. پس از ایجاد کدورت، 3 میلیلیتر از آن با 1 میلیلیتر گزیلن مخلوط شد تا ایندول از فاز آبی وارد فاز گزیلن گردد، سپس 0/5 میلیلیتر معرف کوآکس اضافه شد. ایجاد رنگ صورتی تا قرمز حاکی از مثبت بودن تست ایندول در نظر قرار گرفت. از باکتری اشریشیاکلی بهعنوان کنترل مثبت استفاده شد (16).
تست اوره آز: جهت انجام تست اوره آز، محیط اوره آگار بهصورت اسلنت تهیه شد و بهصورت سطحی و عمقی جدایه روی آن کشت داده شد و سپس در دمای 35 درجه سانتیگراد به مدت 18 تا 24 ساعت انکوبه گردید. رنگ محیط صورتی- قرمز مثبت بودن تست اوره آز را نشان داد. از باکتری پروتئوس میرابیلیس به عنوان باکتری کنترل مثبت استفاده شد (16).
تست مصرف سیترات: محیط سیمون سیترات را بهصورت اسلنت تهیه شد و باکتری بهطور سطحی و عمقی بر روی آن کشت داده شد. تولید رنگ آبی نشان دهنده مصرف سیترات توسط باکتری در نظر گرفته شد. از باکتری اشریشیاکلی بهعنوان باکتری شاهد منفی استفاده شد (16).
تست هیدرولیز ژلاتین: باکتری به محیط ژلاتین در لوله آزمایش تلقیح شد و در دمای 35 درجه سانتیگراد به مدت 2 روز انکوبه گردید. پس از گذشت 24 و 48 ساعت، لولهها در دمای 4 درجه سانتیگراد قرار داده شد. مایع ماندن محیط ژلاتین، مثبت بودن تست هیدرولیز ژلاتین را نشان داد. از باکتری اشریشیاکلی بهعنوان کنترل منفی استفاده شد (16).
تستOxidative Fermentative (OF) : استفاده از محیط اکسیداتیو- فرمانتاتیو (OF) یک روش ساده در تمایز بین مصرف هوازی و بیهوازی کربوهیدرات توسط میکروارگانیزمها است. در این تست از قند گلوکز استفاده گردید و 2 لوله O و F در نظر گرفته شد. با استفاده از آنس، باکتریها تا عمق لولهها تلقیح شدند و سپس در لوله F به میزان 2 میلیلیتر پارافین ریخته شد. همینطور 2 لوله O و F شاهد، بدون تلقیح باکتری در نظر گرفته شد و تمام لولهها در دمای 35 درجه سانتیگراد برای 14 روز انکوبه شدند. تولید اسید ناشی از مصرف قند از طریق تغییر رنگ معرف بروموتیمول بلو از سبز به زرد همراه است. تولید اسید در لوله O نشان دهنده واکنش اکسیداتیو و تولید اسید در هر دو لوله O و F نشان دهنده واکنش فرمانتاتیو بود. ترکیب محیط OF بر حسب 100 میلیلیتر آب مقطر شامل 2 گرم پپتون، 5 گرم سدیم کلراید، 0/3 گرم دیپتاسیم فسفات، 0/03 گرم بروموتیمول بلو، 2/5 گرم آگار و 1 گرم از قند مورد آزمایش بود. بعد از تهیه محیط OF، pH محیط بر روی 7/1 تنظیم شد که در این حالت رنگ محیط سبز خواهد شد (16).
تست بیهوازی: جهت انجام این تست، حدود 75 درصد از یک لوله آزمایش درب پیچدار با محیط کشت (5 گرم پپتون + 3 گرم عصاره مخمر در 1000 میلیلیتر آب مقطر) پر شد و بعد از استریل کردن، باکتری به آن تلقیح گردید. سپس مابقی فضای خالی لوله توسط محیط کشت استریل پر شد. درب لوله بسته شد و ظرف مدت 7 روز در دمای 35 درجه سانتیگراد انکوبه گردید و روزانه کدورت محیط جهت رشد باکتری بررسی شد (17).
تست مصرف منبع کربن جهت رشد: جهت بررسی مصرف منبع کربن توسط باکتری، در لولههای آزمایش مقادیر 1 درصد از منابع کربن مختلف گلوکز، مالتوز، گالاکتوز، لاکتوز، ساکارز، ریبوز، سوربیتول، L-آرابینوز، مانوز، رافینوز، D-زایلوز، مانیتول، تریپتوفان، نشاسته و سلوبیوز بهطور جداگانه به ازای 100 میلیلیتر محیط سنتزی (فاقد گلوکز) اضافه شد. پس از استریل کردن، باکتری به این محیطها تلقیح شد و لولههای آزمایش در دمای 35 درجه سانتیگراد انکوبه شدند. ایجاد کدورت در این محیطها نشان دهنده رشد باکتری بود (18).
تجزیه و تحلیل آماری
آنالیزهای آماری با استفاده از نرمافزار SPSS version 16 انجام شد. نتایج مربوط به شناسایی توالی نوکئوتیدی سویههای جداسازی شده نیز در پایگاه NCBI ثبت و آنالیز همولوژی ترادف انجام گرفت.
نتایج
جداسازی و خالصسازی باکتریها از کرم خاکیL. rubellus : بر اساس اندازه، رنگ، قوام و شکل کلنیهای رشد یافته بر روی محیط نوترینت آگار، تعداد 14 کلنی متفاوت تشخیص داده شد (شکل1). این کلنیها با استفاده از روش کشت خطی و بر روی محیط نوترینت آگار، از هم تفکیک و خالصسازی و به ترتیب از L1 تا L14 شماره گذاری شدند.
نتایج گزینش باکتریهای تولید کننده ماده ضد میکروبی: باکتریهای تولید کننده ماده ضد باکتریایی از طریق ایجاد هاله عدم رشد گزینش شدند. نتایج نشان داد که از بین 14 کلنی تخلیص شده، 3 جدایه (L1، L4 و L7) قادر به تولید هاله عدم رشد بودند که از این میان تنها جدایه L4 توانست در برابر هر چهار باکتری مورد مطالعه هاله عدم رشد تولید کند (جدول1). از آنجا که هدف ما گزینش یک باکتری با بیشترین دامنه تاثیر بر روی باکتریهای مورد مطالعه بود، بنابراین جدایه L4 برای مطالعات بعدی انتخاب گردید.
نتایج شناسایی فیلوژنتیکی باکتری ایزوله شده: پس از استخراج DNA باکتری و انجام PCR جهت تکثیر قطعه 16 SrDNA، محصول PCR بر روی ژل آگارز 1 درصد الکتروفورز شد. در نتیجه آن یک باند در نزدیکی محلbp 1500 در مقایسه با مارکر kb 2 مشاهده شد که حاکی از صحت انجام واکنش تکثیر 16 SrDNA بود (شکل2). با تعیین توالی محصول PCR، 1448 جفت باز نوکلئوتید بهدست آمد که توالی آنها در شکل3 نشان داده شده است. نتایج همانندجویی بهدست آمده با کمک نرمافزار BLAST در NCBI نیز نشان داد که این توالی، 98/96 درصد به توالی نوکلئوتیدی باکتری Peribacillus butanolivorans strain NECC10521 و 98/62 درصد به توالی نوکلئوتیدی باکتریهای Bacillus simplex strain QT421، Bacillus sp. (in: Bacteria) strain SQ7-2 وPeribacillus simplex strain JX7-qm شباهت دارد. در مورد توالی چند گونه از جنسهای Peribacillus وBacillus و در رتبههای بعدی میزان شباهت به 55/98 درصد تقلیل یافت. برای مقایسه بیشتر، نتایج همولوژی و بلاست در سایت NCBI در (جدول2) آورده شده است. همولوژی بهدست آمده با کمک نرمافزار BLAST در NCBI، قرابت باکتری مورد مطالعه را با سایر باکتریها مشخص نمود (جدول2). بر این اساس، درخت فیلوژنتیکی با استفاده از روش Neighbor joining رسم شد که در شکل4 نشان داده شده است. بررسیهای فیلوژنتیکی نشان داد که جدایه L4 دستهای (خوشه) را با سویههای مختلف P. butanolivorans تشکیل میدهد و در این میان بیشترین قرابت را به سویهی SMV514-R2L31 نمایان میسازد. البته این در حالی است که سویهی KG با سایر سویههای این گونه یعنی سویه¬های C2L5D، C2L5C و JN3109 قرابت بسیار زیادی دارد. اما گونه دیگر جنس Bacillus یعنی B. subtilis بهعنوان outliers دستهبندی شد که این امر تاییدی بر تعلق KG به گونه P. butanolivorans بود. همچنان که در این شکل مشخص است، سایر جنسهای باکتریایی یا قارچی نیز هر کدام دستههای جداگانه و دوری را با جدایه KG تشکیل دادند (شکل4). مقادیر Bootstrap بهصورت درصدهایی از 1,000 replications نشان داده شدهاند. مقیاس مورد استفاده، 0/001 جایگزینی به ازای موقعیت هر نوکلئوتید را نشان میدهد.
شکل 1: کلنیهای رشد کرده بر روی محیط نوترینت آگار جدا شده از L. rubellus
جدول 1: قابلیت تولید هاله عدم رشد توسط جدایهها (باکتریهای برون همزیست) علیه باکتریهای مورد مطالعه


شکل 2: (راست) باند 16S rDNA حاصل از PCR با استفاده از الکتروفورز با ژل آگارز 1 درصد؛ (چپ) نمایی از مارکر بهکار گرفته شده در این الکتروفورز

شکل 3: نتایج تعیین توالی S rDNA16 باکتری جداسازی شده
جدول2: نتایج حاصل از بررسی همولوژی توالی ژن 16S rDNAی باکتری ایزوله شده در NCBI



شکل 4: ارتباط فیلوژنتیکی بر اساس توالی ژن 16S rRNA، بین سویه KG و گونههای جنس Peribacillus بر پایه روش Neighbor-joining
شکل 5: نمایی از پلیت حاوی باکتری P. butanolivorans KG بر روی محیط نوترینت آگار
نتایج تستهای تکمیلیمورفولوژیکی و بیوشیمیایی: بهمنظور شناسایی دقیقتر سویه برگزیده، تستهای تکمیلی مورفولوژی و بیوشیمیایی مختلفی بر روی آن انجام گرفت که در ادامه به آنها پرداخته میشود. در شکل5، شکل کلنی این باکتری نشان داده شده است. همانگونه که در شکل مشخص است، باکتری دارای کلنی کرمی رنگ، دایرهای با حاشیه صاف بود.
رنگآمیزی جدایه: نتایج رنگآمیزی گرم در شکل6 نشان داده شده است. همانگونه که در شکل مشخص است، باکتری به رنگ آبی- بنفش (گرم مثبت) و به شکل باسیلی، زنجیرهای و پراکنده دیده شد.
نتایج رنگآمیزی اسپور به روش وارتز-کانکلین: همانطور که در شکل7 نشان داده شده است، نتایج رنگآمیزی اسپور به روش وارتز- کانکلین باکتریهایی قرمز رنگ دارای نقاط سبز رنگ را نشان داد که مبنی بر توانایی باکتری در تولید اسپور بود.
نتایج تست کاتالاز: نتایج تست کاتالاز در شکل 8 نشان داده شده است. همچنانکه در سمت چپ تصویر مشخص است، باکتری مورد مطالعه ما قادر به تولید حباب بوده و بنابراین کاتالاز مثبت است، در حالی که باکتری استرپتوکوکوس پایوژنز در سمت راست تصویر، بهعنوان کنترل قادر به تولید حباب نبود.
نتایج تست اکسیداز: نتایج تست اکسیداز در شکل9 نشان داده شده است. همانطور که در این شکل مشخص است، باکتری P. butanolivorans KG (سمت راست) توانسته است معرف NTPDD را اکسید کرده و ترکیب ایندوفنول به رنگ ارغوانی تیره بوجود آورد که به معنی اکسیداز مثبت بودن آن میباشد. در حالی که باکتری استرپتوکوکوس پایوژنز در سمت چپ تصویر، بهعنوان کنترل قادر به تولید رنگ ارغوانی نبوده است.
نتایج تست حرکت با روش قطره معلق در لام حفرهدار: مشاهدات انجام گرفته در زیر میکروسکوپ نوری در مورد قدرت حرکت باکتری P. butanolivorans KG با استفاده از روش قطره معلق در لام حفرهدار، نشان داد که این باکتری متحرک میباشد.
نتایج تست احیا نیترات به نیتریت، دنیتریفیکاسیون و نیتریفیکاسیون: نتایج تست احیا نیترات به نیتریت توسط باکتری P. butanolivorans KGنشان داد که این باکتری توانسته رنگ دیازونیوم قرمز را بهوجود آورد و لوله آزمایش حاوی محیط استات براث (دارای آمونیوم کلراید بهعنوان تنها منبع نیتروژن) را قرمز رنگ نماید، بنابراین قادر به احیاء نیترات به نیتریت بوده است (شکل10). لازم به ذکر است که باکتری مورد مطالعه قادر به دنیتریفیکاسیون و نیتریفیکاسیون نبود.
نتایج تست ایندول: همانطور که در (شکل11) (سمت راست) نشان داده شده، باکتری P. butanolivorans KG قادر به هیدرولیز اسید آمینه تریپتوفان نبوده و در نتیجه حلقه ایندول تولید نکرده است. بر عکس، در لوله سمت چپ، باکتری اشریشیاکلی حلقه ایندول تولید کرده است که نشان دهنده صحت روش انجام تست می¬باشد. بنابراین باکتری مورد مطالعه ایندول منفی میباشد.
نتایج تست اوره آز: نتایج تست تجزیه اوره در (شکل12) نشان داده شده است. همچنانکه در این شکل مشخص است، باکتری P. butanolivorans KG (سمت چپ تصویر) قادر به تجزیه اوره و در نتیجه تولید رنگ ارغوانی در محیط اوره نبوده است، اما باکتری پروتئوس میرابیلیس (سمت راست تصویر)؛ با تجزیه اوره باعث تغییر رنگ لوله آزمایش به ارغوانی شده است. بنابراین باکتری مورد مطالعه اوره منفی می باشد.
نتایج تست مصرف سیترات: نتیجه این تست توانایی باکتری P. butanolivorans KG در مصرف سیترات بهعنوان تنها منبع کربن موجود در محیط مورد استفاده را در (شکل13) نشان می دهد. همانطور که قابل ملاحظه است، این باکتری (سمت چپ تصویر) با مصرف سیترات باعث تغییر pH و در نتیجه تغییر رنگ محیط از سبز به آبی شده و بنابراین سیترات مثبت است. باکتری اشریشیا کلی (سمت راست تصویر) که بهعنوان شاهد منفی استفاده شده بود قادر به مصرف سیترات نبوده و بنابراین تغییری در رنگ محیط کشت ایجاد نکرده است.
نتایج تست هیدرولیز ژلاتین: نتایج تست هیدرولیز ژلاتین در شکل14 نشان میدهد که باکتری P. butanolivorans KG (تصویر پایین) توانسته است با هیدرولیز ژلاتین باعث سیالیت بیشتر محیط شود و بنابراین ژلاتین مثبت است. اما باکتری اشریشیا کلی (تصویر بالا) بهعنوان کنترل قادر به هیدرولیز ژلاتین نبود.
نتایج تست Oxidative Fermentative (OF) : بر اساس نتایجی که از این تست بدست آمد، مشخص شد که باکتری P. butanolivorans KG در شرایط هوازی (اکسیداتیو) قادر به مصرف گلوکز بوده و بنابراین با تولید متابولیت های اسیدی، باعث تغییر رنگ محیط از سبز به زرد میشود اما در شرایط بیهوازی قادر به تخمیر گلوکز نمی باشد (شکل15).
نتایج تست بی هوازی: بررسیهای انجام گرفته در طی 7 روز نشان داد که باکتری P. butanolivorans KG در محیط کشت حاوی 5 گرم پپتون بعلاوه 3 گرم عصاره مخمر در 1000 میلیلیتر آب مقطر و در شرایط بی هوازی، قادر به رشد نمی باشد.
نتایج تست مصرف منبع کربن جهت رشد: نتایج بررسی رشد و تولید کدورت با منابع مختلف کربنی توسط باکتری P. butanolivorans KG نشان داد که این باکتری قدرت استفاده از منابع کربنی کازئین، مالتوز، گالاکتوز، لاکتوز، ساکارز، ریبوز، سوربیتول، مانوز، L- آرابینوز، مانیتول، رافینوز، نشاسته، سلوبیوز و تریپتوفان را، بهعنوان منابع کربنی نداشت اما قادر بود گلوکز و ژلاتین را هیدرولیز کند. بهطورکلی نتایج تستهای مورفولوژیکی و بیوشیمیایی باکتری مورد مطالعه در (جدول3) خلاصه شده است. در نهایت، بر اساس نتایج بهدست آمده از بررسی های فیلوژنتیکی و تستهای تکمیلی مورفولوژیکی و بیوشیمیایی، سویه مورد مطالعه تحت عنوان Peribacillus butanolivorans KG شناسایی و نام-گذاری گردید. این باکتری در پایگاه داده GenBank با شماره دسترسی OR229899. 1 ثبت شد و در دسترس سایرین قرار گرفت.

شکل 6: نمایی از رنگآمیزی گرم در زیر میکروسکوپ

شکل 7: نمایی از رنگآمیزی اسپور به روش وارتز- کانکلین که در آن اسپورها بهصورت نقاط سبز رنگ در درون باکتریهای قرمز رنگ دیده میشوند

شکل 8: نمایی از نتایج تست کاتالاز. سمت راست: استرپتوکوکوس پایوژنز (کاتالاز منفی) و سمت چپ: P. butanolivorans KG (کاتالاز مثبت)

شکل 9: نمایی از نتایج تست اکسیداز. سمت راست: P. butanolivorans KG (اکسیداز مثبت) و سمت چپ: استرپتوکوکوس پایوژنز (اکسیداز منفی)

شکل 10: نمایی از تست احیاء نیترات به نیتریت که در آن باکتری P. butanolivorans KG توانسته رنگ دیازونیوم قرمز را بهوجود آورد (سمت چپ تصویر) و بنابراین قادر به احیاء نیترات به نیتریت بوده است

شکل 11: نتیجه تست ایندول که در آن باکتری P. butanolivorans KG (سمت راست تصویر) ایندول منفی و باکتری اشریشیاکلی (سمت چپ تصویر) ایندول مثبت است

شکل 12: نمایی تست اوره آز که در آن باکتری P. butanolivorans KG (سمت چپ) اوره آز منفی و باکتری پروتئوس میرابیلیس (سمت راست تصویر) اورهآز مثبت بود

شکل 13: نتایج تست مصرف سیترات که در آن باکتری P. butanolivorans KG (سمت چپ تصویر)، سیترات مثبت و باکتری اشریشیاکلی (سمت راست تصویر) سیترات منفی است

شکل 14: نتایج تست هیدرولیز ژلاتین که در آن باکتری P. butanolivorans KG (تصویر پایین) ژلاتین مثبت بوده و محیط را به فرم مایع در آورد اما باکتری اشریشیاکلی (تصویر بالا) چنینی قابلیتی را نشان نداد

شکل 15: نتایج تست مصرف گلوکز توسط باکتری P. butanolivorans KG. سمت راست (اکسیداتیو) و سمت چپ (تخمیری)
جدول3: مقایسه نتایج تستهای مورفولوژیکی و بیوشیمیایی باکتری مورد مطالعه با سایر باکتریهای مشابه


بحث
این مطالعه با هدف شناسایی باکتریهای برون همزیست کرم خاکی L. rubellus بهعنوان مهارکنندههای رشد برخی از باکتریهای بیماریزا انجام شد. اکثر محققان نتایج امیدوارکنندهای را برای کرم خاکی L. rubellus و درون همزیستهای آن بهعنوان یک عامل ضد میکروبی از بررسی متون گزارش کردهاند. با اینحال، هنوز مطالعات پتانسیل باکتریهای برون همزیست آن بهعنوان مهارکنندههای رشد باکتریهای بیماریزا را پشتیبانی نمیکنند. مقاومت آنتیبیوتیکی یک چالش مداوم بوده است که تقریباً بلافاصله پس از کشف اولیه آنتیبیوتیکها پدیدار شده است و نیاز به توسعه آنتیبیوتیکهای جدید و ترکیبات آنتیبیوتیکی نوآورانهای وجود دارد که بتوانند بهطور مؤثر توسعه مقاومت را کاهش دهند. سالانه بیش از 35000 نفر تنها در ایالات متحده بر اثر عفونتهای مقاوم به آنتیبیوتیک جان خود را از دست میدهند. این امر اهمیت شناسایی جایگزینهای دیگر برای آنتیبیوتیکهایی که مقاومت در برابر آنها ایجاد شده است را نشان میدهد. تقریباً میتوان منشأ همه آنتیبیوتیکهای مورد استفاده فعلی را در باکتریها و قارچهای مشتق شده از خاک ردیابی کرد. باکتریها و قارچهای دخیل در همزیستی، حوزهای است که هنوز برای کشف و توسعه آنتیبیوتیکهای جدید به طور گسترده ناشناخته مانده است (1،19). سیستم همزیستی کرم خاکی یکی از بهترین همزیستیهای دفاعی مورد مطالعه تا به امروز را شامل میشود. بهطور خاص، باکتریهای همزیست کرم خاکی، بینش شگفتانگیزی در مورد مجموعهای از ذرات زیست فعال که توسط بیمهرگان بهکار گرفته میشوند، ارائه دادهاند که نهتنها به برآورده کردن نیازهای غذایی و تولیدمثلی میزبان کمک میکند، بلکه میزبان را قادر میسازد تا در برابر شکارچیان احتمالی، بهویژه حشرات مختلف، دفاع نماید. برخی از این همزیستهای باکتریایی در میزبانهای متعدد شناخته شدهاند، اما بهنظر میرسد اکثر سویهها مختص گونه هستند (20-22). مدتهاست که از کرم خاکی L. rubellus بهعنوان دارو برای درمان انواع بیماریها و بهبود سیستم ایمنی استفاده میشود. عصاره L. rubellus دارای خواص ضد باکتریایی است و میتواند باکتریهای گرم مثبت و گرم منفی را مهار نماید (23،24). L. rubellus دارای یک پپتید ضد میکروبی بهنام لومبریسین 1 است که نقش حیاتی در دفاع طبیعی در برابر میکروبهای بیماریزا ایفا میکند. این پپتید منجر به ایجاد منافذ در دیواره سلولی باکتری میشود. این امر باعث میشود که سیتوپلاسم سلولهای باکتریایی در معرض محیط بیرون قرار گیرد و مرگ باکتری را بهدنبال داشته باشد (25). مطالعات متعددی استفاده از عصاره L. rubellus بهعنوان یک داروی جایگزین برای درمان بیماریهای عفونی مانند تب حصبه (26)، عفونت پریآپیکال (27) و پریودنتیت (28) را گزارش داده¬اند. امروزه نه تنها کرم خاکی L. rubellus، بلکه باکتریهای همزیست L. rubellus دارای فعالیتهای آنتیبیوتیکی نیز بهعنوان دارو استفاده میشوند. باکتریهای برونهمزیست میتوانند نقش مهمی در دفاع از میزبان خود در برابر عوامل بیماریزا ایفا کنند. این باکتریها که روی سطح L. rubellus زندگی میکنند، میتوانند با رقابت با عوامل بیماریزا برای منابع، تولید مواد ضدمیکروبی یا حتی تأثیرگذاری بر پاسخ ایمنی میزبان، از او محافظت کنند (9). بنابراین، غربالگری بیشتر باکتریهای برون همزیست بالقوه کرم L. rubellus. ضرورت دارد. بر اساس مشاهدات فعالیت بازدارندگی، سنجش ما نشان داد که Peribacillus butanolivorans KG جدا شده از باکتریهای برون همزیست کرم خاکی L. rubellus قادر به مهار رشد چهار باکتری بیماریزا شامل باسیلوس سوبتیلیس، استافیلوکوکوس اورئوس، اشریشیاکلی و سودوموناس آئروجینوز بود. بر این اساس میتوان بیان داشت که باکتری Peribacillus butanolivorans KG احتمالا متابولیتی را تولید میکند که قادر به مهار رشد باکتریهای بیماریزا میباشد. این با مطالعه Fiolka و همکاران مطابقت دارد که نشان دادهاند یک باکتری درون همزیست جدا شده از روده میانی کرم خاکی دارای فعالیت ضد مایکوباکتریایی است و فعالیتی را در برابر چهار سویه از مایکوباکتریهای سریع الرشد نشان میدهد (29). در مطالعات دیگری نیز، دو جدایه باکتریایی از کرم Pheretima sp. به نامهای Bacillus choshinensis و Bacillus brevis با خاصیت ضد میکروبی گزارش شده است (30،31).
بر اساس نتایج مطالعه حاضر، از جداسازی Peribacillus butanolivorans KG جدا شده از باکتریهای برون همزیست کرم خاکی L. rubellus، میتوان نتیجه گرفت که Peribacillus butanolivorans KG بهطور مؤثر رشد باکتریهای باسیلوس سوبتیلیس، استافیلوکوکوس اورئوس، اشریشیا کلی و سودوموناس آئروجینوز را مهار میکند و احتمالا پتانسیل عمل بهعنوان آنتیبیوتیک را دارد. علاوه بر این، آنالیز ماهیت متابولیتهای تولیدی Peribacillus butanolivorans KG و انجام مطالعات بیشتر برای بررسی مکانیسمهای مهاری Peribacillus butanolivorans KG علیه باکتریهای بیماریزا توصیه میشود.
نتیجه گیری
نتیجه میگیریم که گونه Peribacillus butanolivorans KG جدا شده از باکتریهای برون همزیست کرم خاکی L. rubellus، با تولید متابولیتی دارای فعالیتهای ضد باکتریایی است و این یافتهها میتواند بهعنوان مبنایی برای جلوگیری از ظهور مقاومت چند دارویی و تولید عوامل ضد باکتریایی مبتنی بر محصولات طبیعی مورد استفاده قرار گیرند.
سپاسگزاری
این مقاله حاصل پایاننامه تحت عنوان "جداسازی باکتری مولد ترکیبات آنتی باکتریال از کرم خاکی (Lumbricus rubellus)" در مقطع کارشناسی ارشد در سال 1402 دانشگاه آزاد اسلامی واحد خرم آباد میباشد که با حمایت دانشگاه آزاد اسلامی واحد خرم آباد انجام شده است.
ملاحظات اخلاقی
پروپوزال این تحقیق توسط کمیته ملی اخلاق در پژوهشهای زیست پزشکی دانشگاه آزاد اسلامی تایید شده است (کد اخلاق: IR.IAU.SHK.REC.1403.025).
مشارکت نویسندگان
فرهاد گیلاوند در ارائه ایده، فرهاد گیلاوند، امیر ارسلان کاویانی فرد و بهروز دوستی در طراحی مطالعه، محمد بهرامینژاد در جمعآوری دادهها، محمد بهرامینژاد و نجمه مولوی وردنجانی در تجزیه و تحلیل دادهها مشارکت داشته و همه نویسندگان در تدوین، ویرایش اولیه و نهایی مقاله و پاسخگویی به سوالات مرتبط با مقاله سهیم هستند.
References:
1- Gogineni V, Chen X, Hanna G, Mayasari D, Hamann MT. Role of Symbiosis in the Discovery of Novel Antibiotics. J Antibiot (Tokyo) 2020; 73(8): 490-503.
2- Gross M. The Race Against Antibiotics Resistance. Current Biology 2019; 29(18): 859-61.
3- Engl T, Kroiss J, Kai M, Nechitaylo TY, Svatoš A, Kaltenpoth M. Evolutionary Stability of Antibiotic Protection in a Defensive Symbiosis. Proc Natl Acad Sci USA 2018; 115(9): E2020-29.
4- Zhang X, Wei W, Tan R. Symbionts, A Promising Source of Bioactive Natural Products. Science China Chemistry 2015; 58(7): 1097-109.
5- Adnani N, Rajski SR, Bugni TS. Symbiosis-Inspired Approaches to Antibiotic Discovery. Nat Prod Rep 2017; 34(7): 784-814.
6- Montaser R, Luesch H. Marine Natural Products: A New Wave of Drugs? Future Med Chem 2011; 3(12): 1475-89.
7- Nwankwo IU, Edward KC, Udensi CG. Screening of Bacteria Isolates from Earthworm Cast for Antibacterial Activities. Scientia Africana 2023; 22(2): 83-94.
8- Hobbelen PH, Koolhaas JE, van Gestel CA. Bioaccumulation of Heavy Metals in the Earthworms Lumbricus Rubellus and Aporrectodea Caliginosa in Relation to Total and Available Metal Concentrations in Field Soils. Environ Pollut 2006; 144(2): 639-46.
9- Ramadhar TR, Beemelmanns C, Currie CR, Clardy J. Bacterial Symbionts in Agricultural Systems Provide a Strategic Source for Antibiotic Discovery. J Antibiot 2014; 67(1): 53-8.
10- Saadoun I, Muhana A. Optimal Production Conditions, Extraction, Partial Purification and Characterization of Inhibitory Compound (S) Produced by Streptomyces Ds-104 Isolate Against Multi-Drug Resistant Candida Albicans. Current Trends in Biotechnology and Pharmacy 2(2): 402-32.
11- Kyule DN, Maingi JM, Njeru EM, Nyamache AK. Molecular Characterization and Diversity of Bacteria Isolated from Fish and Fish Products Retailed in Kenyan Markets. Int J Food Sci 2022; 2022: 2379323.
12- Hamouda T, Shih AY, Baker JR Jr. A Rapid Staining Technique for the Detection of the Initiation of Germination of Bacterial Spores. Lett Appl Microbiol 2002; 34(2): 86-90.
13- Khatoon H, Chavan DD, Anokh A, Kalia V. Catalase Test: A Biochemical Protocol for Bacterial Identification. AgriCos e-Newsletter 2022; 3(1): 53-5.
14- Dharmappa DC, Anokhe A, Kalia V. Oxidase Test: A Biochemical Methods in Bacterial Identification. AgriCos e-Newsletter 2022; 3(1): 31-3.
15- Jain A, Jain R, Jain S. Motility Testing–Hanging Drop Method and Stab. Basic Techniques in Biochemistry, Microbiology and Molecular Biology: Principles and Techniques. New York, NY: Springer US 2020; 121-22.
16- Aslanzadeh J. Biochemical Profile-Based Microbial Identification Systems. Advanced Techniques in Diagnostic Microbiology. Boston, MA: Springer US 2006; 84-116.
17- Mayorga M, Rodríguez-Cavallini E, López-Ureña D, Barquero-Calvo E, Quesada-Gómez C. Identification and Antimicrobial Susceptibility of Obligate Anaerobic Bacteria from Clinical Samples of Animal Origin. Anaerobe 2015; 36: 19-24.
18- Garland JL, Mills AL. Classification and Characterization of Heterotrophic Microbial Communities on the Basis of Patterns of Community-Level Sole-Carbon-Source Utilization. Appl Environ Microbiol 1991; 57(8): 2351-9.
19- Engl T, Kroiss J, Kai M, Nechitaylo TY, Svatoš A, Kaltenpoth M. Evolutionary Stability of Antibiotic Protection in a Defensive Symbiosis. Proc Natl Acad Sci USA 2018; 115(9): E2020-E2029.
20- Eleftherianos I, Shokal U, Yadav S, Kenney E, Maldonado T. Insect Immunity to Entomopathogenic Nematodes and their Mutualistic Bacteria. Curr Top Microbiol Immunol 2017; 402: 123-56.
21- Lacey LA, Grzywacz D, Shapiro-Ilan DI, Frutos R, Brownbridge M, Goettel MS. Insect Pathogens as Biological Control Agents: Back to the Future. J Invertebr Pathol 2015; 132: 1-41.
22- Adnani N, Rajski SR, Bugni TS. Symbiosis-Inspired Approaches to Antibiotic Discovery. Nat Prod Rep 2017; 34(7): 784-814.
23- Foekh NP, Sukrama IDM, Lestari AAW. The Ability of Earthworm Lumbricus Rubellus Extract in Slowing Down the Activation of Nfkb and TNF-Α in Lipopolysaccharide-Induced Rattus Norvegicus. Bali Med J 2019; 8(2): 439.
24- Sun Z. Earthworm as A Biopharmaceutical: From Traditional to Precise. Eur J Bio Med Res 2015; 1(2): 28.
25- Dadgostar P. Antimicrobial Resistance: Implications and Costs. Infect Drug Resist 2019; 12: 3903-10.
26- Lestari AAW, Made Sukrama ID, Nurmansyah D. The Earthworm (Lumbricus Rubellus) Extract Decreased Amino Transaminase Enzyme Level and Number of Bacterial Colony in Male Wistar Rats Infected with Salmonella Typhimurium. Biomed Pharmacol J 2019; 12(1): 325-32.
27- Andayani R, Mubarak Z, Rinanda DR. Aktivitas Antibakteri Tepung Cacing Tanah (Lumbricus Rubellus) Terhadap Enterococcus Faecalis Secara In Vitro. J Syiah Kuala Dent Soc 2016; 1(2): 201-10.
28- Dharmawati IGAA, Mahadewa TGB, Widyadharma IPE. Antibacterial Activity of Lumbricus Rubellus Earthworm Extract Against Porphyromonas Gingivalis as the Bacterial Cause of Periodontitis. Open Access Maced J Med Sci 2019; 7(6): 1032-6.
29- Fiołka MJ, Zagaja MP, Piersiak TD, Wróbel M, Pawelec J. Gut Bacterium of Dendrobaena Veneta (Annelida: Oligochaeta) Possesses Antimycobacterial Activity. J Invertebr Pathol 2010; 105(1): 63-73. doi:
30- Samanta TT, Das A. Isolation, Identification, and Characterization of Gut Microflora of Perionyx Excavatus Collected from Midnapore, West Bengal. J Basic Microbiol 2016; 56(3): 286-93.
31- Tikhonov V, Zavgorodnyaya J, Demin V, Byzov B. Transformation of Soil Humic Acids by Aporrectodea Caliginosa Earthworm: Effect of Gut Fluid and Gut Associated Bacteria. European Journal of Soil Biology 2016; 75: 47-53.
1- Gogineni V, Chen X, Hanna G, Mayasari D, Hamann MT. Role of Symbiosis in the Discovery of Novel Antibiotics. J Antibiot (Tokyo) 2020; 73(8): 490-503.
2- Gross M. The Race Against Antibiotics Resistance. Current Biology 2019; 29(18): 859-61.
3- Engl T, Kroiss J, Kai M, Nechitaylo TY, Svatoš A, Kaltenpoth M. Evolutionary Stability of Antibiotic Protection in a Defensive Symbiosis. Proc Natl Acad Sci USA 2018; 115(9): E2020-29.
4- Zhang X, Wei W, Tan R. Symbionts, A Promising Source of Bioactive Natural Products. Science China Chemistry 2015; 58(7): 1097-109.
5- Adnani N, Rajski SR, Bugni TS. Symbiosis-Inspired Approaches to Antibiotic Discovery. Nat Prod Rep 2017; 34(7): 784-814.
6- Montaser R, Luesch H. Marine Natural Products: A New Wave of Drugs? Future Med Chem 2011; 3(12): 1475-89.
7- Nwankwo IU, Edward KC, Udensi CG. Screening of Bacteria Isolates from Earthworm Cast for Antibacterial Activities. Scientia Africana 2023; 22(2): 83-94.
8- Hobbelen PH, Koolhaas JE, van Gestel CA. Bioaccumulation of Heavy Metals in the Earthworms Lumbricus Rubellus and Aporrectodea Caliginosa in Relation to Total and Available Metal Concentrations in Field Soils. Environ Pollut 2006; 144(2): 639-46.
9- Ramadhar TR, Beemelmanns C, Currie CR, Clardy J. Bacterial Symbionts in Agricultural Systems Provide a Strategic Source for Antibiotic Discovery. J Antibiot 2014; 67(1): 53-8.
10- Saadoun I, Muhana A. Optimal Production Conditions, Extraction, Partial Purification and Characterization of Inhibitory Compound (S) Produced by Streptomyces Ds-104 Isolate Against Multi-Drug Resistant Candida Albicans. Current Trends in Biotechnology and Pharmacy 2(2): 402-32.
11- Kyule DN, Maingi JM, Njeru EM, Nyamache AK. Molecular Characterization and Diversity of Bacteria Isolated from Fish and Fish Products Retailed in Kenyan Markets. Int J Food Sci 2022; 2022: 2379323.
12- Hamouda T, Shih AY, Baker JR Jr. A Rapid Staining Technique for the Detection of the Initiation of Germination of Bacterial Spores. Lett Appl Microbiol 2002; 34(2): 86-90.
13- Khatoon H, Chavan DD, Anokh A, Kalia V. Catalase Test: A Biochemical Protocol for Bacterial Identification. AgriCos e-Newsletter 2022; 3(1): 53-5.
14- Dharmappa DC, Anokhe A, Kalia V. Oxidase Test: A Biochemical Methods in Bacterial Identification. AgriCos e-Newsletter 2022; 3(1): 31-3.
15- Jain A, Jain R, Jain S. Motility Testing–Hanging Drop Method and Stab. Basic Techniques in Biochemistry, Microbiology and Molecular Biology: Principles and Techniques. New York, NY: Springer US 2020; 121-22.
16- Aslanzadeh J. Biochemical Profile-Based Microbial Identification Systems. Advanced Techniques in Diagnostic Microbiology. Boston, MA: Springer US 2006; 84-116.
17- Mayorga M, Rodríguez-Cavallini E, López-Ureña D, Barquero-Calvo E, Quesada-Gómez C. Identification and Antimicrobial Susceptibility of Obligate Anaerobic Bacteria from Clinical Samples of Animal Origin. Anaerobe 2015; 36: 19-24.
18- Garland JL, Mills AL. Classification and Characterization of Heterotrophic Microbial Communities on the Basis of Patterns of Community-Level Sole-Carbon-Source Utilization. Appl Environ Microbiol 1991; 57(8): 2351-9.
19- Engl T, Kroiss J, Kai M, Nechitaylo TY, Svatoš A, Kaltenpoth M. Evolutionary Stability of Antibiotic Protection in a Defensive Symbiosis. Proc Natl Acad Sci USA 2018; 115(9): E2020-E2029.
20- Eleftherianos I, Shokal U, Yadav S, Kenney E, Maldonado T. Insect Immunity to Entomopathogenic Nematodes and their Mutualistic Bacteria. Curr Top Microbiol Immunol 2017; 402: 123-56.
21- Lacey LA, Grzywacz D, Shapiro-Ilan DI, Frutos R, Brownbridge M, Goettel MS. Insect Pathogens as Biological Control Agents: Back to the Future. J Invertebr Pathol 2015; 132: 1-41.
22- Adnani N, Rajski SR, Bugni TS. Symbiosis-Inspired Approaches to Antibiotic Discovery. Nat Prod Rep 2017; 34(7): 784-814.
23- Foekh NP, Sukrama IDM, Lestari AAW. The Ability of Earthworm Lumbricus Rubellus Extract in Slowing Down the Activation of Nfkb and TNF-Α in Lipopolysaccharide-Induced Rattus Norvegicus. Bali Med J 2019; 8(2): 439.
24- Sun Z. Earthworm as A Biopharmaceutical: From Traditional to Precise. Eur J Bio Med Res 2015; 1(2): 28.
25- Dadgostar P. Antimicrobial Resistance: Implications and Costs. Infect Drug Resist 2019; 12: 3903-10.
26- Lestari AAW, Made Sukrama ID, Nurmansyah D. The Earthworm (Lumbricus Rubellus) Extract Decreased Amino Transaminase Enzyme Level and Number of Bacterial Colony in Male Wistar Rats Infected with Salmonella Typhimurium. Biomed Pharmacol J 2019; 12(1): 325-32.
27- Andayani R, Mubarak Z, Rinanda DR. Aktivitas Antibakteri Tepung Cacing Tanah (Lumbricus Rubellus) Terhadap Enterococcus Faecalis Secara In Vitro. J Syiah Kuala Dent Soc 2016; 1(2): 201-10.
28- Dharmawati IGAA, Mahadewa TGB, Widyadharma IPE. Antibacterial Activity of Lumbricus Rubellus Earthworm Extract Against Porphyromonas Gingivalis as the Bacterial Cause of Periodontitis. Open Access Maced J Med Sci 2019; 7(6): 1032-6.
29- Fiołka MJ, Zagaja MP, Piersiak TD, Wróbel M, Pawelec J. Gut Bacterium of Dendrobaena Veneta (Annelida: Oligochaeta) Possesses Antimycobacterial Activity. J Invertebr Pathol 2010; 105(1): 63-73. doi:
30- Samanta TT, Das A. Isolation, Identification, and Characterization of Gut Microflora of Perionyx Excavatus Collected from Midnapore, West Bengal. J Basic Microbiol 2016; 56(3): 286-93.
31- Tikhonov V, Zavgorodnyaya J, Demin V, Byzov B. Transformation of Soil Humic Acids by Aporrectodea Caliginosa Earthworm: Effect of Gut Fluid and Gut Associated Bacteria. European Journal of Soil Biology 2016; 75: 47-53.
ارسال پیام به نویسنده مسئول
| بازنشر اطلاعات | |
 |
این مقاله تحت شرایط Creative Commons Attribution-NonCommercial 4.0 International License قابل بازنشر است. |







